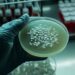
Alerta por Fiebre hemorrágica en Córdoba: suman seis los casos en total

Ocurrió el jueves por la tarde en barrio Alberdi, cuando un comerciante circulaba en su camioneta y delincuentes le reventaron la ventanilla para sustraerle dos mochilas con dinero
Un hombre sufrió el jueves por la tarde un violento asalto, en barrio Alberdi.
Mientras circulaba en su camioneta, el comerciante fue emboscado por motochoros que se apoderaron de una suma millonaria destinada al pago de sueldos.
El robo sucedió en la intersección de Figueroa Alcorta y calle Santa Rosa, en las inmediaciones del colegio Jerónimo Luis de Cabrera. Los malvivientes le reventaron la ventanilla del vehículo y sustrajeron dos mochilas que contenían cerca de 12 millones de pesos.
Antes del asalto, el comerciante había cambiado dólares en una financiera del Centro. Según las primeras hipótesis de los investigadores, habría un entregador, ya que los delincuentes siguieron a la víctima varias cuadras hasta concretar el hecho.
Pese al operativo policial desplegado, los ladrones logaron darse a la fuga. Afortunadamente, no hubo que lamentar heridos.